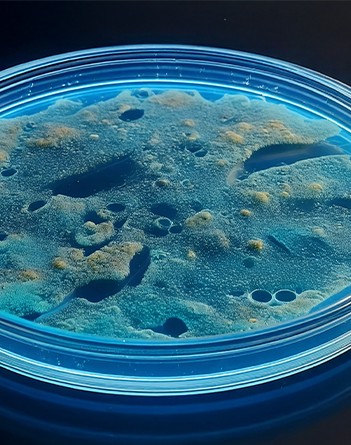

Wenn Sie sich sicher sein wollen, sind wir der richtige Partner. Ganz sicher.
Bei CERTANIA profitieren Sie von einem einzigartigen Netzwerk aus Experten und Spezialisten. Mit diesem umfassenden und weitreichendem Fachwissen stellen wir sicher, dass Ihre Produkte und Dienstleistungen globalen Standards entsprechen.